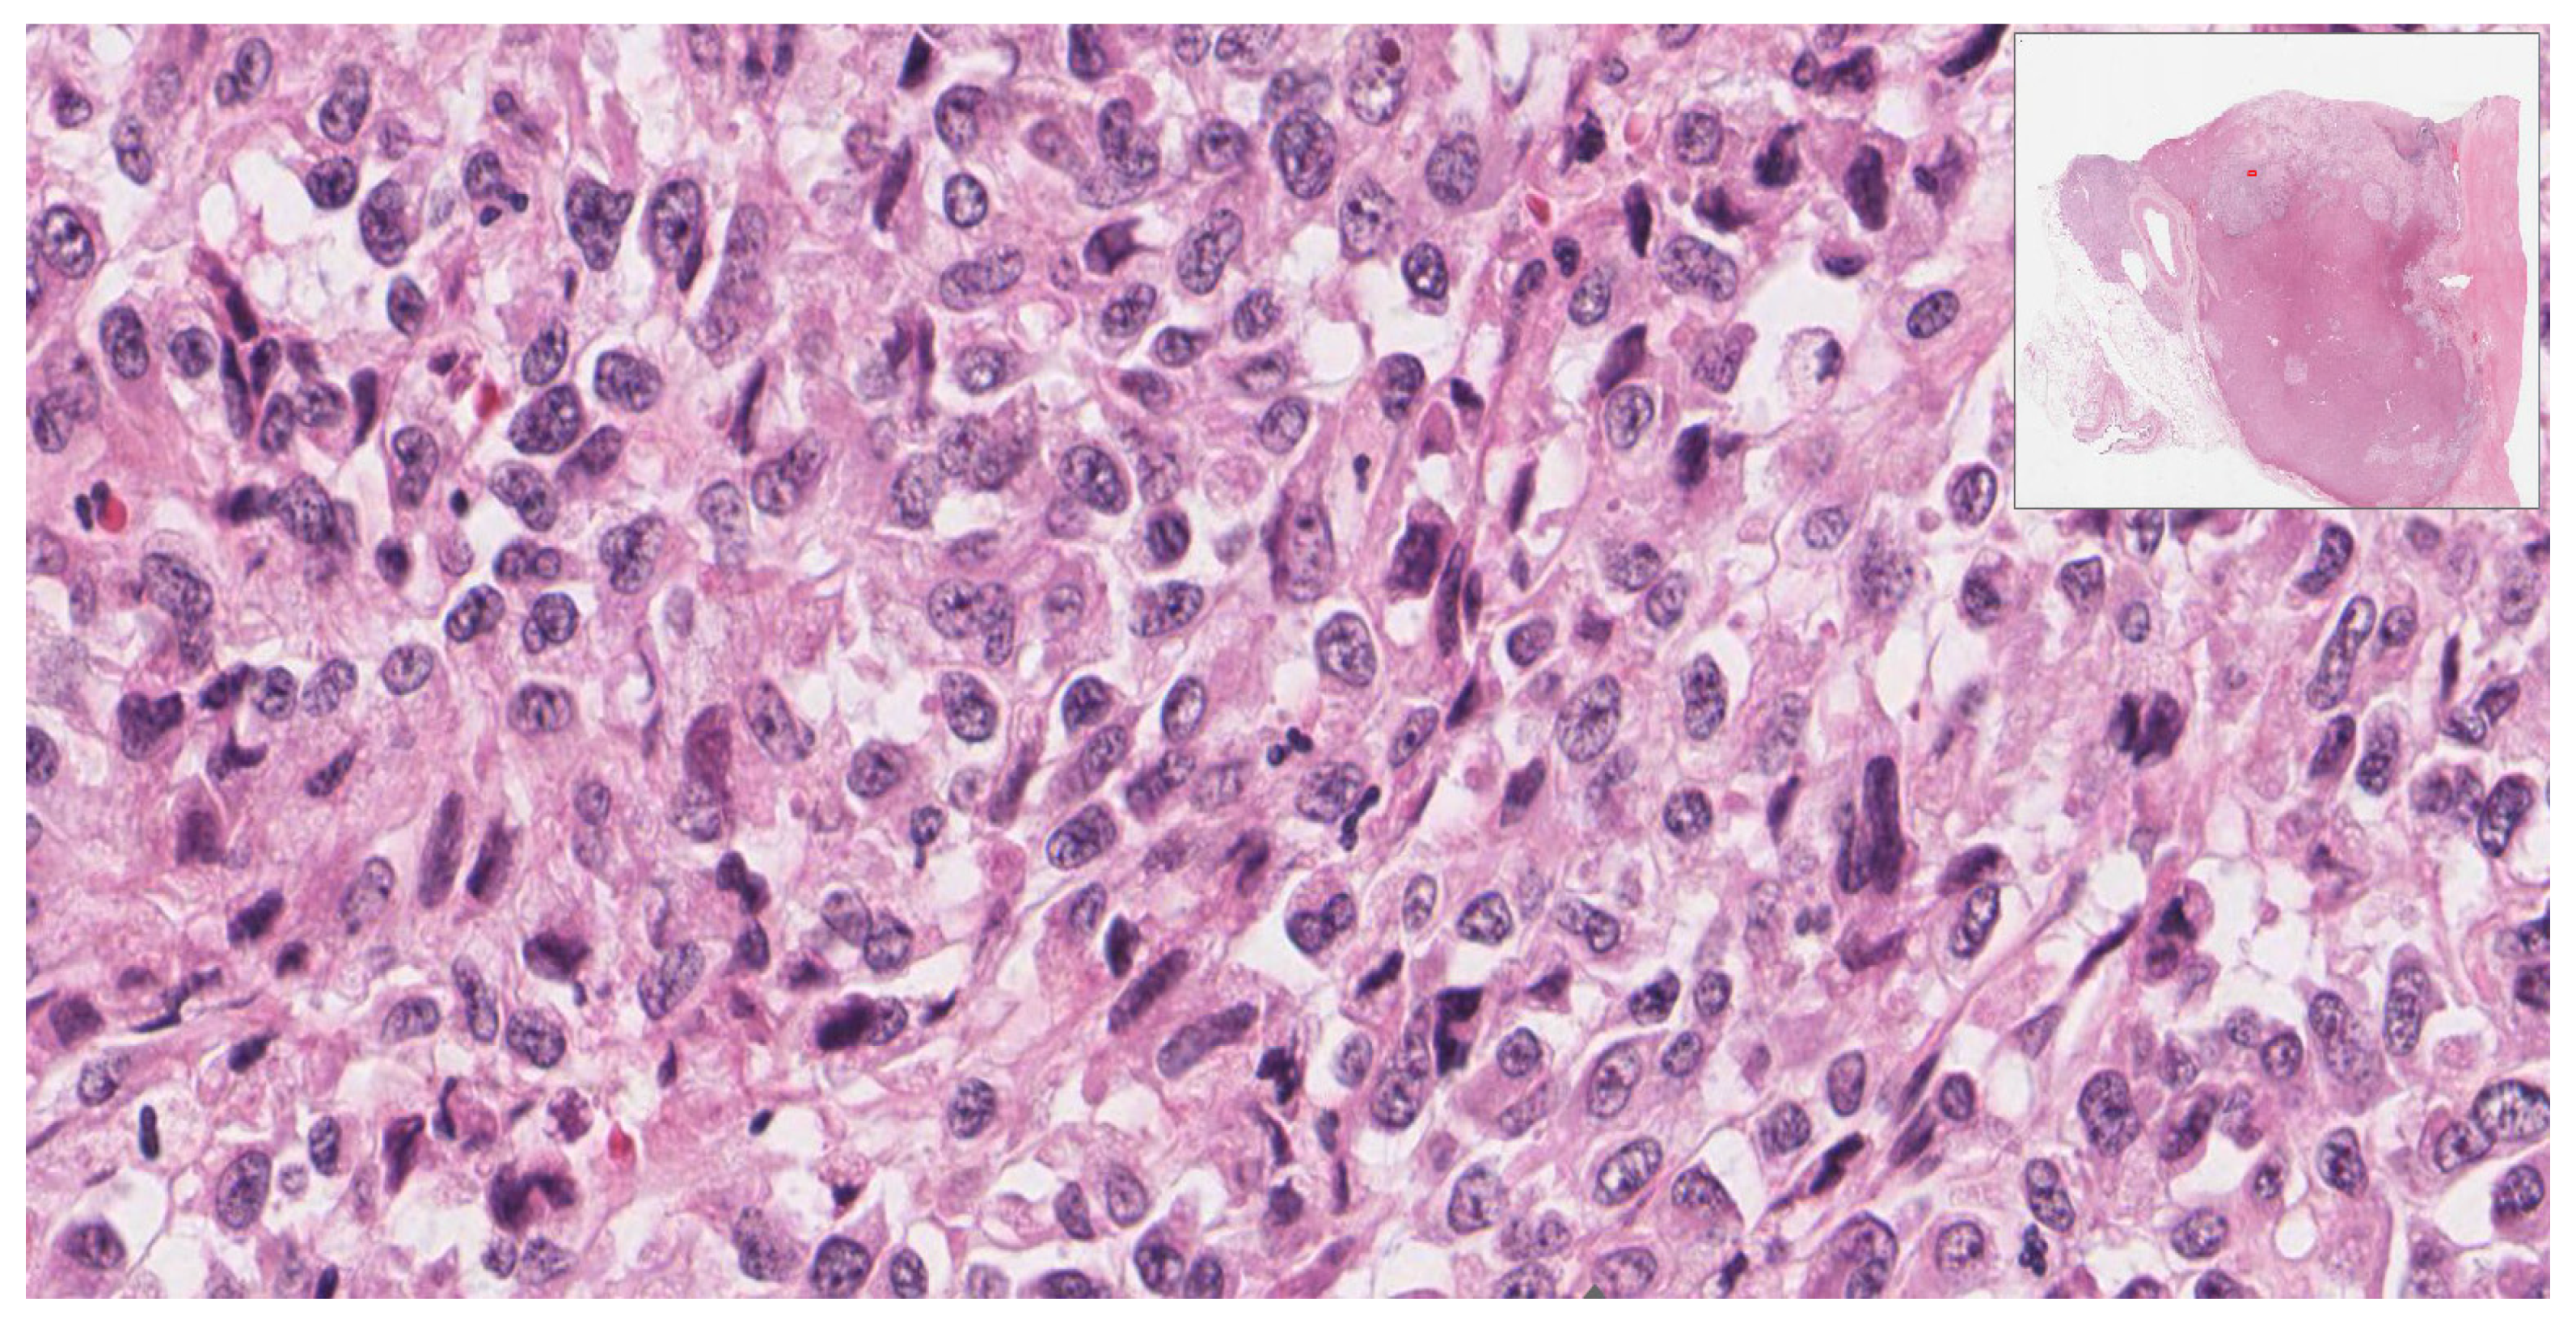
Diagnostics 12 02419 g004 Diagnostics 12 02419 g004

Insights into Clinical Features and Outcomes of Adrenal Cortical Carcinosarcoma
Abstract
1. Introduction
2. Case Presentation
3. Literature Review
4. Discussion
5. Conclusions
Author Contributions
Funding
Institutional Review Board Statement
Informed Consent Statement
Data Availability Statement
Conflicts of Interest
References
- Lam, A. Adrenocortical Carcinoma: Updates of Clinical and Pathological Features after Renewed World Health Organisation Classification and Pathology Staging. Biomedicines 2021, 9, 175. [Google Scholar] [CrossRef] [PubMed]
- Okazumi, S.; Asano, T.; Ryu, M.; Nagashima, T.; Odaka, M.; Isono, K.; Nishizawa, T. Surgical Resection of Adrenal Carcinoma Extending into the Vena Cava, Right Atrium and Ventricle: Case Report and Review of the Literature. Nihon Geka Gakkai Zasshi 1987, 88, 231–238. Available online: https://europepmc.org/article/med/3574283 (accessed on 7 August 2022). (In Japanese). [PubMed]
- IIshikawa, N.; Nagase, M.; Takami, S.; Araki, A.; Ishikawa, N.; Koike, C.; Shiina, H.; Maruyama, R. A Case Report of Bilateral Sarcomatoid Carcinoma of Adrenal Glands With Adrenal Insufficiency. Int. J. Surg. Pathol. 2016, 24, 743–748. [Google Scholar] [CrossRef] [PubMed]
- Sturm, N.; Moulai, N.; Laverrière, M.-H.; Chabre, O.; Descotes, J.-L.; Brambilla, E. Primary adrenocortical sarcomatoid carcinoma: Case report and review of literature. Virchows Arch. 2007, 452, 215–219. [Google Scholar] [CrossRef]
- Collina, G.; Maldarizzi, F.; Betts, C.M.; Eusebi, V. Primary sarcomatoid carcinoma of the adrenal gland. First case report. Virchows Arch. A Pathol. Anat. Histopathol. 1989, 415, 161–167. [Google Scholar] [CrossRef] [PubMed]
- Decorato, J.W.; Gruber, H.; Petti, M.; Levowitz, B.S. Adrenal carcinosarcoma. J. Surg. Oncol. 1990, 45, 134–136. [Google Scholar] [CrossRef] [PubMed]
- Fischler, D.F.; Nunez, C.; Levin, H.S.; McMahon, J.T.; Sheeler, L.R.; Adelstein, D.J. Adrenal Carcinosarcoma Presenting in a Woman With Clinical Signs of Virilization A Case Report With Immunohistochemical and Ultrastructural Findings. Am. J. Surg. Pathol. 1992, 16, 626–631. [Google Scholar] [CrossRef]
- Barksdale, S.K.; Marincola, F.M.; Jaffe, G. Carcinosarcoma of the Adrenal Cortex Presenting with Mineralocorticoid Excess. Am. J. Surg. Pathol. 1993, 17, 941–945. [Google Scholar] [CrossRef]
- Lee, M.S.; Park, I.A.; Chi, J.G.; Ham, E.K.; Lee, K.C.; Lee, C.W. Adrenal carcinosarcoma—A case report. J. Korean Med. Sci. 1997, 12, 374–377. [Google Scholar] [CrossRef]
- Chung, J.W.; Lee, K.J.; Lee, J.H.; Kim, H.L.; Moon, G.; Lee, B.K.; Kim, D.M.; Bae, H.Y.; Lim, S.C. A Case of Adrenal Carcinosarcoma. J. Korean Cancer Assoc. 1998, 30, 620–624. [Google Scholar]
- Somda, F.; Leger, J.; Guy, L.; Norha, O.; Desbiez, F.; Boiteux, J.; Kemeny, J.; Thieblot, P.; Tauveron, I. Adrenocortical Carcinosarcoma: First European Case Report. Endocrine Abstracts. Vol. 14. Bioscientifica, 2007. Available online: https://www.endocrine-abstracts.org/ea/0014/ea0014p98.htm?utm_source=TrendMD&utm_medium=cpc&utm_campaign=Endocrine_Abstracts._TrendMD_0 (accessed on 7 August 2022).
- Coli, A.; Di Giorgio, A.; Castri, F.; Destito, C.; Marin, A.W.; Bigotti, G. Sarcomatoid carcinoma of the adrenal gland: A case report and review of literature. Pathol. Res. Pr. 2010, 206, 59–65. [Google Scholar] [CrossRef] [PubMed]
- Sasaki, K.; Desimone, M.; Rao, H.R.; Huang, G.J.; Seethala, R.R. Adrenocortical carcinosarcoma: A case report and review of the literature. Diagn. Pathol. 2010, 5, 51. [Google Scholar] [CrossRef] [PubMed]
- Yang, Z.-G.; Su, X.-Y.; Wang, Q.-L.; Feng, Y.-C.; Chen, T.-W.; Deng, W. Adrenal sarcomatoid carcinoma: A rare case depicted on multi-detector row computed tomography. Indian J. Med. Sci. 2010, 64, 37–40. [Google Scholar] [CrossRef]
- Bertolini, F.; Rossi, G.; Fiocchi, F.; Giacometti, M.; Fontana, A.; Gibertini, M.C.; Roncucci, L.; Luppi, G.; Torricelli, P.; Rossi, A.; et al. Primary adrenal gland carcinosarcoma associated with metastatic rectal cancer: A hitherto unreported collision tumor. Tumori J. 2011, 97, e27–e30. [Google Scholar] [CrossRef]
- Thway, K.; Olmos, D.; Shah, C.; Flora, R.; Shipley, J.; Fisher, C. Oncocytic Adrenal Cortical Carcinosarcoma With Pleomorphic Rhabdomyosarcomatous Metastases. Am. J. Surg. Pathol. 2012, 36, 470–477. [Google Scholar] [CrossRef] [PubMed]
- Yan, J.-J.; Sun, A.-J.; Ren, Y.; Hou, C. Primary adrenocortical sarcomatoid carcinoma: Report of a case. Can. Urol. Assoc. J. 2012, 6, E189. [Google Scholar] [CrossRef] [PubMed]
- Kao, C.S.; Grignon, D.J.; Ulbright, T.M.; Idrees, M.T. A Case Report of Adrenocortical Carcinosarcoma with Oncocytic and Primitive Neuroectodermal-like Features. Hum. Pathol. 2013, 44, 1947–1955. Available online: https://www.sciencedirect.com/science/article/pii/S004681771300052X?casa_token=khyrzobm3mIAAAAA:AjDm7-Ps27igu9zYjm9ZLFGOCurr4rl8XRT3fxiTlSfnQ-JFZFFjmq9gCulkwHYIEkIrnLulzg (accessed on 7 August 2022). [CrossRef]
- Mark, D.; Boyd, C.; Eatock, F. Adrenal Sarcomatoid Carcinoma: A case report and review of the literature. Ulster Med. J. 2014, 83, 89–92. [Google Scholar]
- Shaikh, A.S.; Bakhshi, G.D.; Khan, A.S.; Jamadar, N.M.; Nirmala, A.K.; Raza, A.A. Primary Adrenal Sarcomatoid Carcinoma. Clin. Pr. 2014, 4, 604. [Google Scholar] [CrossRef]
- Wei, Y.; Gao, Y.-L.; Wu, H.-T.; Ou-Yang, S.-F.; Xu, T.; Mao, D.-F.; Yang, J.-R. Rare incidence of primary adrenocortical carcinosarcoma: A case report and literature review. Oncol. Lett. 2014, 9, 153–158. [Google Scholar] [CrossRef][Green Version]
- Wanis, K.N.; Kanthan, R. Diagnostic and prognostic features in adrenocortical carcinoma: A single institution case series and review of the literature. World J. Surg. Oncol. 2015, 13, 1–13. [Google Scholar] [CrossRef] [PubMed]
- Zhu, C.; Zheng, A.; Mao, X.; Shi, B.; Li, X. Primary adrenal sarcomatoid carcinoma metastatic to the lung: Case report and review of the literature. Oncol. Lett. 2016, 11, 3117–3122. [Google Scholar] [CrossRef] [PubMed][Green Version]
- Iyidir, O.T.; Cerit, E.T.; Özkan, Ç.; Altınova, E.; Çimen, A.R.; Sozen, S.; Kerem, M.; Akturk, M.; Memiş, L.; Törüner, B.; et al. A Case Report of Bilateral Adrenal Sarcomatoid Carcinoma. Case Report 2016, 2016, 3768258. [Google Scholar] [CrossRef]
- Papathomas, T.G.; Duregon, E.; Korpershoek, E.; Restuccia, D.F.; van Marion, R.; Cappellesso, R.; Sturm, N.; Rossi, G.; Coli, A.; Zucchini, N.; et al. Sarcomatoid adrenocortical carcinoma: A comprehensive pathological, immunohistochemical, and targeted next-generation sequencing analysis. Hum. Pathol. 2016, 58, 113–122. [Google Scholar] [CrossRef]
- Saeger, W.; Mohren, W.; Behrend, M.; Iglauer, P.; Wilczak, W. Sarcomatoid Adrenal Carcinoma: Case Report with Contribution to Pathogenesis. Endocr. Pathol. 2016, 28, 139–145. [Google Scholar] [CrossRef]
- Sung, T.-Y.; Choi, Y.M.; Kim, W.B.; Lee, Y.-M.; Kim, T.Y.; Shong, Y.K.; Song, D.E. Myxoid and Sarcomatoid Variants of Adrenocortical Carcinoma: Analysis of Rare Variants in Single Tertiary Care Center. J. Korean Med. Sci. 2017, 32, 764–771. [Google Scholar] [CrossRef] [PubMed]
- Gulec, Y.M.; Cankurtaran, Y.; Gonca, O.G.; Onder, P.B.; Arıkan, E.D. A Adrenocortical Carcinoma (ACC) Presenting with Episodes of Intermittent Hypertension: Sarcomatoid Type Adrenocortical Carcinoma. Endocrine Abstracts. Volume 63. Bioscientifica, 2019. Available online: https://www.endocrine-abstracts.org/ea/0063/ea0063p847.htm (accessed on 7 August 2022).
- Sabrine, D.; Zakia, B.; Kaoutar, Z. Adrenocortical Sarcomatoid Carcinoma: A Case Report and Review of the Literature. J. Surg. Case Rep. 2020, 2020, rjaa211. Available online: https://academic.oup.com/jscr/article/2020/7/rjaa211/5872069 (accessed on 7 August 2022). [CrossRef] [PubMed]
- Rezwana, I.; Sarkar, S.; Rouf, R.S.B.; Shefin, S.M.; Ashrafuzzaman, S. Sarcomatoid Carcinoma of Adrenal Gland: A Rare Case Report. BIRDEM Med. J. 2019, 10, 73–75. Available online: https://www.banglajol.info/index.php/BIRDEM/article/view/44766 (accessed on 7 August 2022). [CrossRef][Green Version]
- Rachh, S.; Nilam, P. Metastatic Bilateral Adrenal Sarcomatoid Carcinoma: Evaluation by 18F-FDG PET/CT. Nucl. Med. Biol. 2022, 2, 10. Available online: https://aojnmb.mums.ac.ir/article_19619.html (accessed on 7 August 2022).
- Zhang, J.; Gong, W.; Zhang, W.; Zhang, C.; Zhang, G. Primary Adrenal Sarcomatoid Carcinoma Detected by 18F-FDG PET/CT. Clin. Nucl. Med. 2022, 47, 433–434. Available online: https://journals.lww.com/nuclearmed/Abstract/2022/05000/Primary_Adrenal_Sarcomatoid_Carcinoma_Detected_by.10.aspx (accessed on 7 August 2022). [CrossRef]
- Fassnacht, M.; Arlt, W.; Bancos, I.; Dralle, H.; Newell-Price, J.; Sahdev, A.; Tabarin, A.; Terzolo, M.; Tsagarakis, S.; Dekkers, O.M. Management of adrenal incidentalomas: European society of endocrinology clinical practice guideline in collabo-ration with the European network for the study of adrenal tumors. Eur. J. Endocrinol. 2016, 175, G1–G34. [Google Scholar] [CrossRef] [PubMed]
- Loh, T.L.; Tomlinson, J.; Chin, R.; Eslick, G.D. Cutaneous Carcinosarcoma with Metastasis to the Parotid Gland. Case Rep. Otolaryngol. 2014, 2014, 1–4. [Google Scholar] [CrossRef] [PubMed]
- Münz, M.; Kieu, C.; Mack, B.; Schmitt, B.; Zeidler, R.; Gires, O. The carcinoma-associated antigen EpCAM upregulates c-myc and induces cell proliferation. Oncogene 2004, 23, 5748–5758. [Google Scholar] [CrossRef] [PubMed]
- Vitale, S.G.; Laganà, A.S.; Capriglione, S.; Angioli, R.; La Rosa, V.L.; Lopez, S.; Valenti, G.; Sapia, F.; Sarpietro, G.; Butticè, S.; et al. Target Therapies for Uterine Carcinosarcomas: Current Evidence and Future Perspectives. Int. J. Mol. Sci. 2017, 18, 1100. [Google Scholar] [CrossRef]
- Fields, A.L.; Keller, A.; Schwartzberg, L.; Bernard, S.; Kardinal, C.; Cohen, A.; Schulz, J.; Eisenberg, P.; Forster, J.; Wissel, P. Adjuvant Therapy With the Monoclonal Antibody Edrecolomab Plus Fluorouracil-Based Therapy Does Not Improve Overall Survival of Patients With Stage III Colon Cancer. J. Clin. Oncol. 2009, 27, 1941–1947. [Google Scholar] [CrossRef]
- Litvinov, S.V.; Velders, M.P.; Bakker, H.A.; Fleuren, G.J.; Warnaar, S.O. Ep-CAM: A human epithelial antigen is a homophilic cell-cell adhesion molecule. J. Cell Biol. 1994, 125, 437–446. [Google Scholar] [CrossRef]
- Spizzo, G.; Went, P.; Dirnhofer, S.; Obrist, P.; Moch, H.; Baeuerle, P.A.; Mueller-Holzner, E.; Marth, C.; Gastl, G.; Zeimet, A.G. Overexpression of epithelial cell adhesion molecule (Ep-CAM) is an independent prognostic marker for reduced survival of patients with epithelial ovarian cancer. Gynecol. Oncol. 2006, 103, 483–488. [Google Scholar] [CrossRef]
- Ferrari, F.; Bellone, S.; Black, J.; Schwab, C.L.; Lopez, S.; Cocco, E.; Bonazzoli, E.; Predolini, F.; Menderes, G.; Litkouhi, B.; et al. Solitomab, an EpCAM/CD3 bispecific antibody construct (BiTE®), is highly active against primary uterine and ovarian carcinosarcoma cell lines in vitro. J. Exp. Clin. Cancer Res. 2015, 34, 1–8. [Google Scholar] [CrossRef]
- Kebenko, M.; Goebeler, M.-E.; Wolf, M.; Hasenburg, A.; Seggewiss-Bernhardt, R.; Ritter, B.; Rautenberg, B.; Atanackovic, D.; Kratzer, A.; Rottman, J.B.; et al. A multicenter phase 1 study of solitomab (MT110, AMG 110), a bispecific EpCAM/CD3 T-cell engager (BiTE®) antibody construct, in patients with refractory solid tumors. OncoImmunology 2018, 7, e1450710. [Google Scholar] [CrossRef]
- Baudin, E.; Leboulleux, S.; Al Ghuzlan, A.; Chougnet, C.; Young, J.; Deandreis, D.; Dumont, F.; Dechamps, F.; Caramella, C.; Chanson, P.; et al. Therapeutic management of advanced adrenocortical carcinoma: What do we know in 2011? Horm. Cancer 2011, 2, 363–371. [Google Scholar] [CrossRef]
- Berruti, A.; Baudin, E.; Gelderblom, H.; Haak, H.R.; Porpiglia, F.; Fassnacht, M.; Pentheroudakis, G. Adrenal cancer: ESMO Clinical Practice Guidelines for diagnosis, treatment and follow-up. Ann. Oncol. 2012, 23, vii131–vii138. [Google Scholar] [CrossRef] [PubMed]
- Costa, R.; Carneiro, B.A.; Tavora, F.; Pai, S.G.; Kaplan, J.B.; Chae, Y.K.; Chandra, S.; Kopp, P.A.; Giles, F.J. The Challenge of Developmental Therapeutics for Adrenocortical Carcinoma. Oncotarget 2016, 7, 46734–46749. Available online: https://www.oncotarget.com/article/8774/text/ (accessed on 7 August 2022). [CrossRef] [PubMed][Green Version]
- Gotoh, O.; Sugiyama, Y.; Takazawa, Y.; Kato, K.; Tanaka, N.; Omatsu, K.; Takeshima, N.; Nomura, H.; Hasegawa, K.; Fujiwara, K.; et al. Clinically relevant molecular subtypes and genomic alteration-independent differentiation in gynecologic carcinosarcoma. Nat. Commun. 2019, 10, 1–14. [Google Scholar] [CrossRef] [PubMed]

| Stain | Carcinomatous Component | Sarcomatous Component | Company | Clone |
|---|---|---|---|---|
| Calretinin | Positive | Negative | Ventana | SP65 |
| HMB-45 | Negative | Negative | Ventana | HMB-65 |
| Inhibin Alpha | Positive | Negative | Ventana | R1 |
| Synaptophysin | Positive | Negative | Ventana | SP11 |
| Myogenin | Negative | Negative | Ventana | F5D |
| Vimentin | Negative | Positive | Ventana | Vim 3B4 |
| Desmin | Negative | Positive | Ventana | DE-R-11 |
| Pax8 | Negative | Negative | Ventana | MRQ-50 |
| Pan-keratin | Negative | Negative | Ventana | AE1/AE3/PCK 26 |
| Author | Age/Sex | Chief Complaint | Endocrine Dysfunction | Location | Metastasis at Presentation | Size (cm), Weight (g) | Sarcomatous Component | Treatment | Outcome |
|---|---|---|---|---|---|---|---|---|---|
| Okazumi et al., 1987 [2] | 46/M | Abdominal distention, back pain | No | R | Invasion of tumor emboli to RA, RV, IVC, and retroperitoneum | 14 cm, 880 g | Spindle Cell | Adrenalectomy and nephrectomy | Death at 6 months post-op |
| Collina et al., 1989 [5] | 68/F | Abdominal discomfort | No | L | No | 11 cm, Not reported | Spindle Cell | Resection | Recurrence at 2 months, Death at 6 months post-op (7 months after diagnosis) |
| Decorato et al., 1990 [6] | 42/F | Abdominal and flank pain | No | L | No | 19 cm, 1400 g | Rhabdomyosarcoma | Resection | Death at 7 months post-op |
| Fischler et al., 1992 [7] | 29/F | Amenorrhea, fatigue, weight loss, body musculature, clitoromegaly, hirsutism | Yes | L | No | 12.5 cm, 610 g | Rhabdomyosarcoma | Resection with adjuvant treatment with mitotane | Death at 8 months post-op |
| Barksdale et al., 1993 [8] | 79/F | Severe hypertension | Yes | R | Invasion of IVC | 9 cm, 199 g | Osteosarcoma, chondrosarcoma | Not reported | Not reported |
| Lee et al., 1997 [9] | 61/M | Flank and back pain | Yes | R | Liver | 12 cm, no weight reported | Spindle cell | Radical nephrectomy, right liver lobectomy | Death at 2 days post-op |
| Chung et al., 1998 [10] | 48/F | Abdominal distention | No | R | No | Not reported | Spindle cell | Resection | Death 3 months post-op |
| Somda et al., 2007 [11] | 58/F | Asthenia and flank pain | No | R | No | 13 cm, 760 g | Leiomyosarcoma | Adrenalectomy, nephrectomy, adjuvant treatment with mitotane | Alive without recurrence after 16 months |
| Sturm et al., 2008 [4] | 31/M | Abdominal pain | No | L | No | 12 cm, 620 gm | Spindle Cell | Resection with cisplatin and etoposide | Death at 3 months post-op |
| Coli et al., 2010 [12] | 75/F | Abdominal pain | No | L | No | 15 cm, not reported | Spindle cell | Adrenalectomy and splenectomy | Death at 12 months post-op |
| Sasaki et. Al., 2010 [13] | 45/M | Abdominal Pain, Fever, Nausea and vomiting | No | L | Left retroperitoneal invasion and bi-lobar liver metastasis | 17 cm, 2974 g | Rhabdomyosarcoma | Nephrectomy, splenectomy, partial colectomy, and pancreatectomy | Death at 3 months post-op |
| Feng et al., 2010 [14] | 72/M | Lumbar back pain | No | L | No | 7.1 cm, not reported | Spindle cell | Resection | Not reported |
| Bertolini et al., 2011 [15] | 23/F | Fatigue, decreased appetite, fixed mass in rectum | No | L | None from the primary adrenocortical carcinoma. This was a collision tumor with an adrenal metastasis of a rectal tumor | 14 cm, Not reported | Osteosarcoma | adrenalectomy | Death at 14 months post-op |
| Thway et al., 2012 [16] | 45/M | Bloating, back pain | No | L | Abdominal and retroperitoneal nodes, lung | 24 cm, 6500 g | Rhabdomyosarcoma | Adrenalectomy, splenectomy, nephrectomy + combination high-dose palliative chemotherapy of vincristine, ifosfamide, doxorubicin, and etoposide, alternating with ifosfamide, carboplatin, and etoposide. | Death at 11 months post-op |
| Yan et al., 2012 [17] | 72/M | Flank pain | No | R | Pulmonary nodules | 13 cm, not reported | Spindle cell | adrenalectomy | Death at 2.5 years post-op |
| Kao et al., 2013 [18] | 45/M | Abdominal pain, weight loss | No | R | No | 15 cm, 760 g | Spindle cell | Partial nephrectomy and hepatectomy | Death at 7 months post-op |
| Mark et al., 2014 [19] | 58/M | Flank pain | No | R | No | 12 cm, 573 g | Spindle cell | Adrenalectomy and nephrectomy | No evidence of metastatic adrenal disease at 17 months |
| Shaikh et al., 2014 [20] | 62/F | RUQ pain | No | R | Not at presentation, Para-aortic lymph nodes, 3 months after adrenalectomy | 6.5 cm, 55 g | Spindle cell | adrenalectomy | Death at 4 months post-op, having declined adjuvant therapy |
| Wei et al., 2015 [21] | 63/F | Fatigue, flank pain | No | L | No | 8 cm, not reported | Spindle cell | adrenalectomy | No recurrence at one month post-op |
| Wanis et al., 2015 [22] | 68/F | Incidental finding during follow-up of lung adenocarcinoma | No | Unspecified | No | 13 cm, not reported | Spindle cell | Radical nephrectomy | Death at 223 days post-op |
| Wanis et al., 2015 [22] | 65/M | Incidental finding during claudication work-up | No | Unspecified | No | 12.8 cm, not reported | Spindle cell | Radical nephrectomy | Alive at 4 months; unknown total survival |
| Zhu et al., 2016 [23] | 59/M | Asthenia and weight loss | No | R | Lung | 5 cm, not reported | Spindle cell | adrenalectomy | Alive at 6 months post op, refused further treatment and follow up |
| Ishikawa et al., 2016 [3] | 69/F | General malaise and hypotension | Yes | Bilateral | No | R–5.5 cm, 20 g; L–7 cm 35 g | Not reported | Resection | 4 months post-op |
| Iyidir et al., 2016 [24] | 53/F | Abdominal and flank pain, weight loss | No | Bilateral | Liver | R-9 cm, 80 g; L-8.5 cm, not reported | Spindle cell | Bilateral adrenalectomy, splenectomy, cholecystectomy, partial hepatectomy and nephrectomy | Death 1 month post-op due to pancreatic fistula development and multiorgan failure |
| Papathomas et al., 2016 [25] | 55/M | Abdominal pain | No | L | No | 16 cm, not reported | Spindle Cell | Resection | Death at 4 months from diagnosis |
| Papathomas et al., 2016 [25] | 70/F | Abdominal pain, diarrhea | No | R | No | 15 cm, not reported | Osteosarcoma, Spindle cell | Resection and mitotane | Death at 8 months from diagnosis |
| Papathomas et al., 2016 [25] | 52/M | Abdominal pain, fatigue, malaise, weight loss | No | R | Liver | 24 cm, 3020 g | Spindle Cell | Resection and mitotane | Death at 4.5 months from diagnosis |
| Saeger et al., 2017 [26] | 53/F | Hypertension | Yes | R | Liver | 13 cm, not reported | Spindle cell | Adrenalectomy and partial hepatectomy | Alive > 6 months post-op; alive at time of article but survival duration not clear |
| Sung et al., 2017 [27] | 51/M | “Nonspecific” | No | R | Liver, spleen, lung | 15 cm, not reported | Spindle cell | Resection | Death at 1.7 months |
| Yazir et al., 2019 [28] | 52/M | Abdominal pain and distention, episodic hypertension | Yes | L | Spleen | 14 cm, not reported | Not reported | Resection | Death at 1 day post-op |
| Sabrine et al., 2020 [29] | 27/F | Flank pain | No | R | No | 12 cm, 660 g | Spindle cell | Adrenalectomy | Alive at 6 months follow up without local recurrence |
| Rexwana et al., 2020 [30] | 37/F | Facial swelling and flushing, weight gain, palpitations, RUQ abdominal pain, generalized weakness and lethargy | Yes | R | No | 10 cm, not reported | Osteosarcoma | Adrenalectomy | Alive 5 months post-op, received 3 rd cycle of chemotherapy |
| Rachh & Nilam, 2022 [31] | 78/F | Severe back pain | No | Bilateral | Bone, lymph nodes, pleura | R-4.6 cm; L-6.0 cm | Spindle cell | Not reported | Death within few months of diagnosis |
| Zhang et al., 2022 [32] | 53/M | RUQ abdominal pain | No | R | Mediastinal Lymph Node | 7.2 cm | Not reported | Surgical resection of the mass + immune therapy | 6 months after diagnosis |
| Present Case | 78/F | Fatigue and shoulder pain | No | R | No | 27 cm, 3307 g | Spindle cell | Radical nephrectomy and adrenalectomy, partial hepatectomy | Death at 7 days post-op |
Publisher’s Note: MDPI stays neutral with regard to jurisdictional claims in published maps and institutional affiliations. |
© 2022 by the authors. Licensee MDPI, Basel, Switzerland. This article is an open access article distributed under the terms and conditions of the Creative Commons Attribution (CC BY) license (https://creativecommons.org/licenses/by/4.0/).
Share and Cite
Branham, Z.; Fox, A.D.; Ullah, A.; Patel, N.G.; Terris, M.; Parikh, J. Insights into Clinical Features and Outcomes of Adrenal Cortical Carcinosarcoma. Diagnostics 2022, 12, 2419. https://doi.org/10.3390/diagnostics12102419
Branham Z, Fox AD, Ullah A, Patel NG, Terris M, Parikh J. Insights into Clinical Features and Outcomes of Adrenal Cortical Carcinosarcoma. Diagnostics. 2022; 12(10):2419. https://doi.org/10.3390/diagnostics12102419
Chicago/Turabian StyleBranham, Zachery, Ashley D. Fox, Asad Ullah, Nikhil G. Patel, Martha Terris, and Jigarkumar Parikh. 2022. "Insights into Clinical Features and Outcomes of Adrenal Cortical Carcinosarcoma" Diagnostics 12, no. 10: 2419. https://doi.org/10.3390/diagnostics12102419
APA StyleBranham, Z., Fox, A. D., Ullah, A., Patel, N. G., Terris, M., & Parikh, J. (2022). Insights into Clinical Features and Outcomes of Adrenal Cortical Carcinosarcoma. Diagnostics, 12(10), 2419. https://doi.org/10.3390/diagnostics12102419

